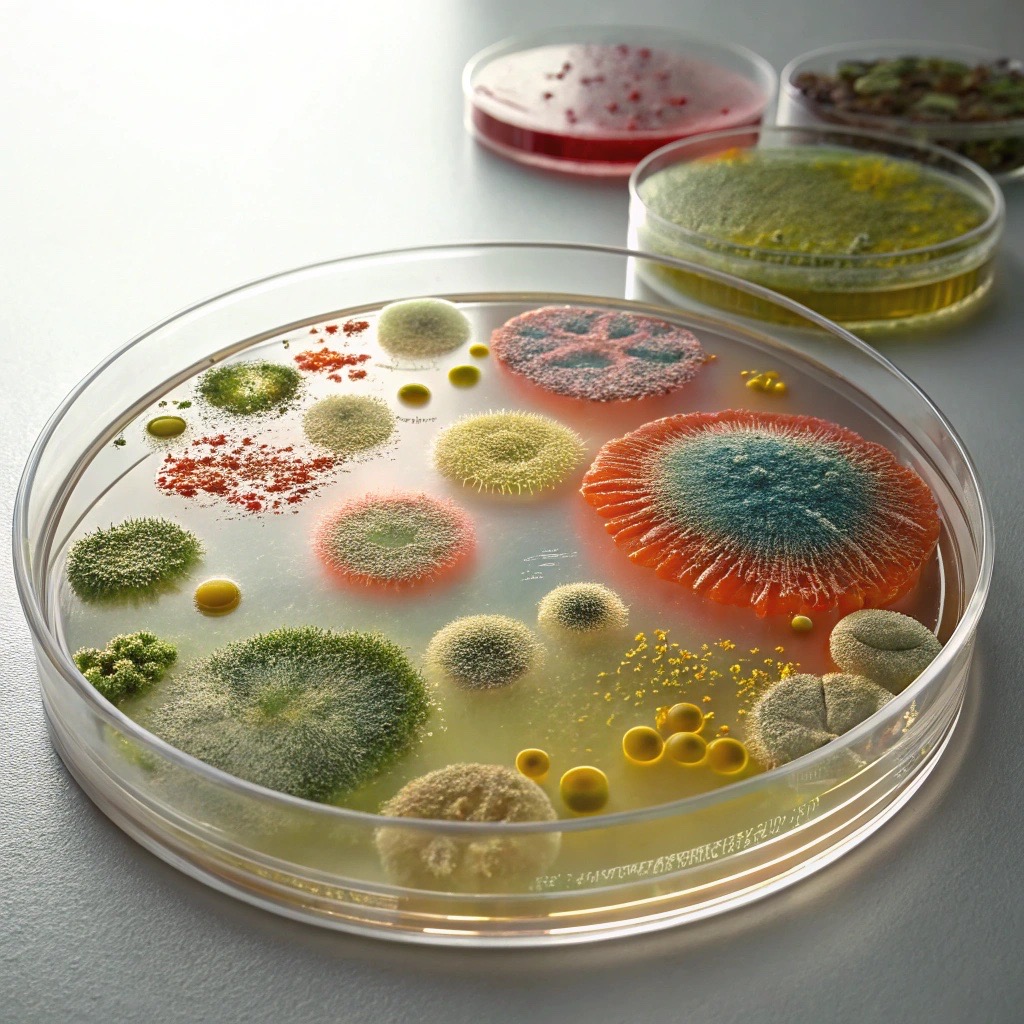

It starts with smart consultation. We help design experiments aligned with your goals. Post-sequencing, we take care of the heavy lifting—processing, analyzing, and interpreting your data to deliver insights that drive decisions.
Introducing AMPLICLOUD: Your Easy Solution for Amplicon-seq Analysis
At Nova Lifetech, we make amplicon-seq analysis easy.
Our streamlined pipelines transform complex sequencing data into clear, actionable insights. Whether you’re exploring microbial diversity or comparing communities across conditions, we deliver fast, scalable, and user-friendly solutions designed for both researchers and industry.





